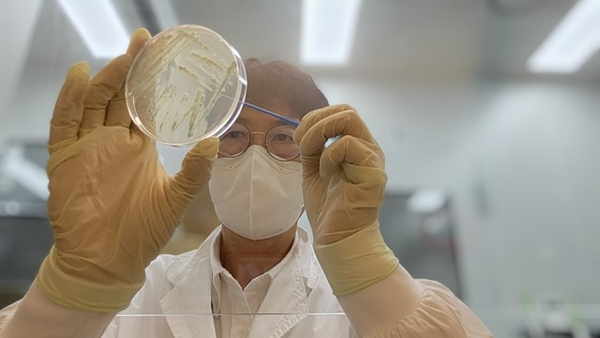

5¿ù ÇØ¼ö¼ ºñºê¸®¿ÀÆÐÇ÷Áõ±Õ °ËÃ⡦ ¿©¸§Ã¶ ÇØ»ê¹° ÁÖÀÇ ´çºÎ ¡Û ¾îÆÐ·ù »ý½Ä¡¤»óó ÅëÇÑ °¨¿° À§Çè. ´ç´¢º´¡¤°£ÁúȯÀÚ µî °íÀ§Ç豺 ƯÈ÷ ÁÖÀÇ |
| 2025-06-05(¸ñ) 08:44 |
|
ºñºê¸®¿ÀÆÐÇ÷ÁõÀº ÁÖ·Î 5~6¿ù¿¡ ¹ß»ýÇØ 8~9¿ù¿¡ °¡Àå ¸¹ÀÌ ³ªÅ¸³ª¸ç, ¾îÆÐ·ù¸¦ »ý½ÄÇϰųª ÇǺΠ»óó¿¡ ¿À¿°µÈ ÇØ¼ö°¡ ´êÀ¸¸é °¨¿°µÉ ¼ö ÀÖ´Ù.
ÃÖ±Ù 3³â°£ °æ±âµµ °¨¿° »ç·Ê´Â 2022³â 13¸í, 2023³â 9¸í, 2024³â 16¸íÀ¸·Î Áý°èµÆ´Ù.
ºñºê¸®¿ÀÆÐÇ÷ÁõÀº °¨¿° ½Ã ±Þ¼º ¹ß¿, ¿ÀÇÑ, º¹Åë, ±¸Åä, ¼³»ç µîÀÇ Áõ»óÀÌ ³ªÅ¸³ª°í, ÇǺο¡´Â ºÎÁ¾, ¹ßÁø, ±«»ç¼º º´º¯ µîÀÌ »ý±æ ¼ö ÀÖ´Ù. ƯÈ÷ ¸¸¼º °£ÁúȯÀÚ, ´ç´¢º´ ȯÀÚ, ¸é¿ªÀúÇÏÀÚ, ¾ËÄÚ¿Ã Áßµ¶ÀÚ µî °íÀ§Ç豺Àº °¨¿° ½Ã Ä¡¸í·üÀÌ ³ô¾Æ °¢º°ÇÑ ÁÖÀǰ¡ ÇÊ¿äÇÏ´Ù.
ºñºê¸®¿ÀÆÐÇ÷Áõ±ÕÀº ¿°µµ 1~3%ÀÇ ÇØ¼ö¿¡¼ Áõ½ÄÇϴ ȣ¿°¼º ¼¼±ÕÀ̹ǷÎ, ¾îÆÐ·ù ¼·Ãë ½Ã ¹Ýµå½Ã È帣´Â ¼öµ¾¹°¿¡ ¼¼Ã´ÇÑ ÈÄ 85¡É À̻󿡼 ÃæºÐÈ÷ °¡¿ Á¶¸®ÇØ¾ß ÇÑ´Ù. ÇØ¾ç Ȱµ¿ ½Ã¿¡´Â ÇǺο¡ »óó°¡ »ý±âÁö ¾Êµµ·Ï ÁÖÀÇÇϰí, ¹°³îÀÌ ÈÄ¿¡´Â ºñ´©¸¦ »ç¿ëÇØ ±ú²ýÀÌ ¾Ä´Â °ÍÀÌ Áß¿äÇÏ´Ù.
°æ±âµµº¸°Çȯ°æ¿¬±¸¿ø ÀüÁ¾¼· ¼öÀμºÁúȯÆÀÀåÀº ¡°ºñºê¸®¿ÀÆÐÇ÷ÁõÀº Á¶±â ¿¹¹æÀÌ ¹«¾ùº¸´Ù Áß¿äÇÑ Áúȯ¡±À̶ó¸ç ¡°¾îÆÐ·ù ¹Ýµå½Ã ÀÍÇô ¸Ô±â, Á¶¸® ½Ã Àå°© Âø¿ë, »óó°¡ ÀÖÀ» °æ¿ì ¹Ù´å¹° Á¢ÃË ±ÝÁö µî ¿¹¹æ ¼öÄ¢À» öÀúÇÏ°Ô ÁöÄÑ´Þ¶ó¡±°í ´çºÎÇß´Ù.


2026.03.27(±Ý) 15:48